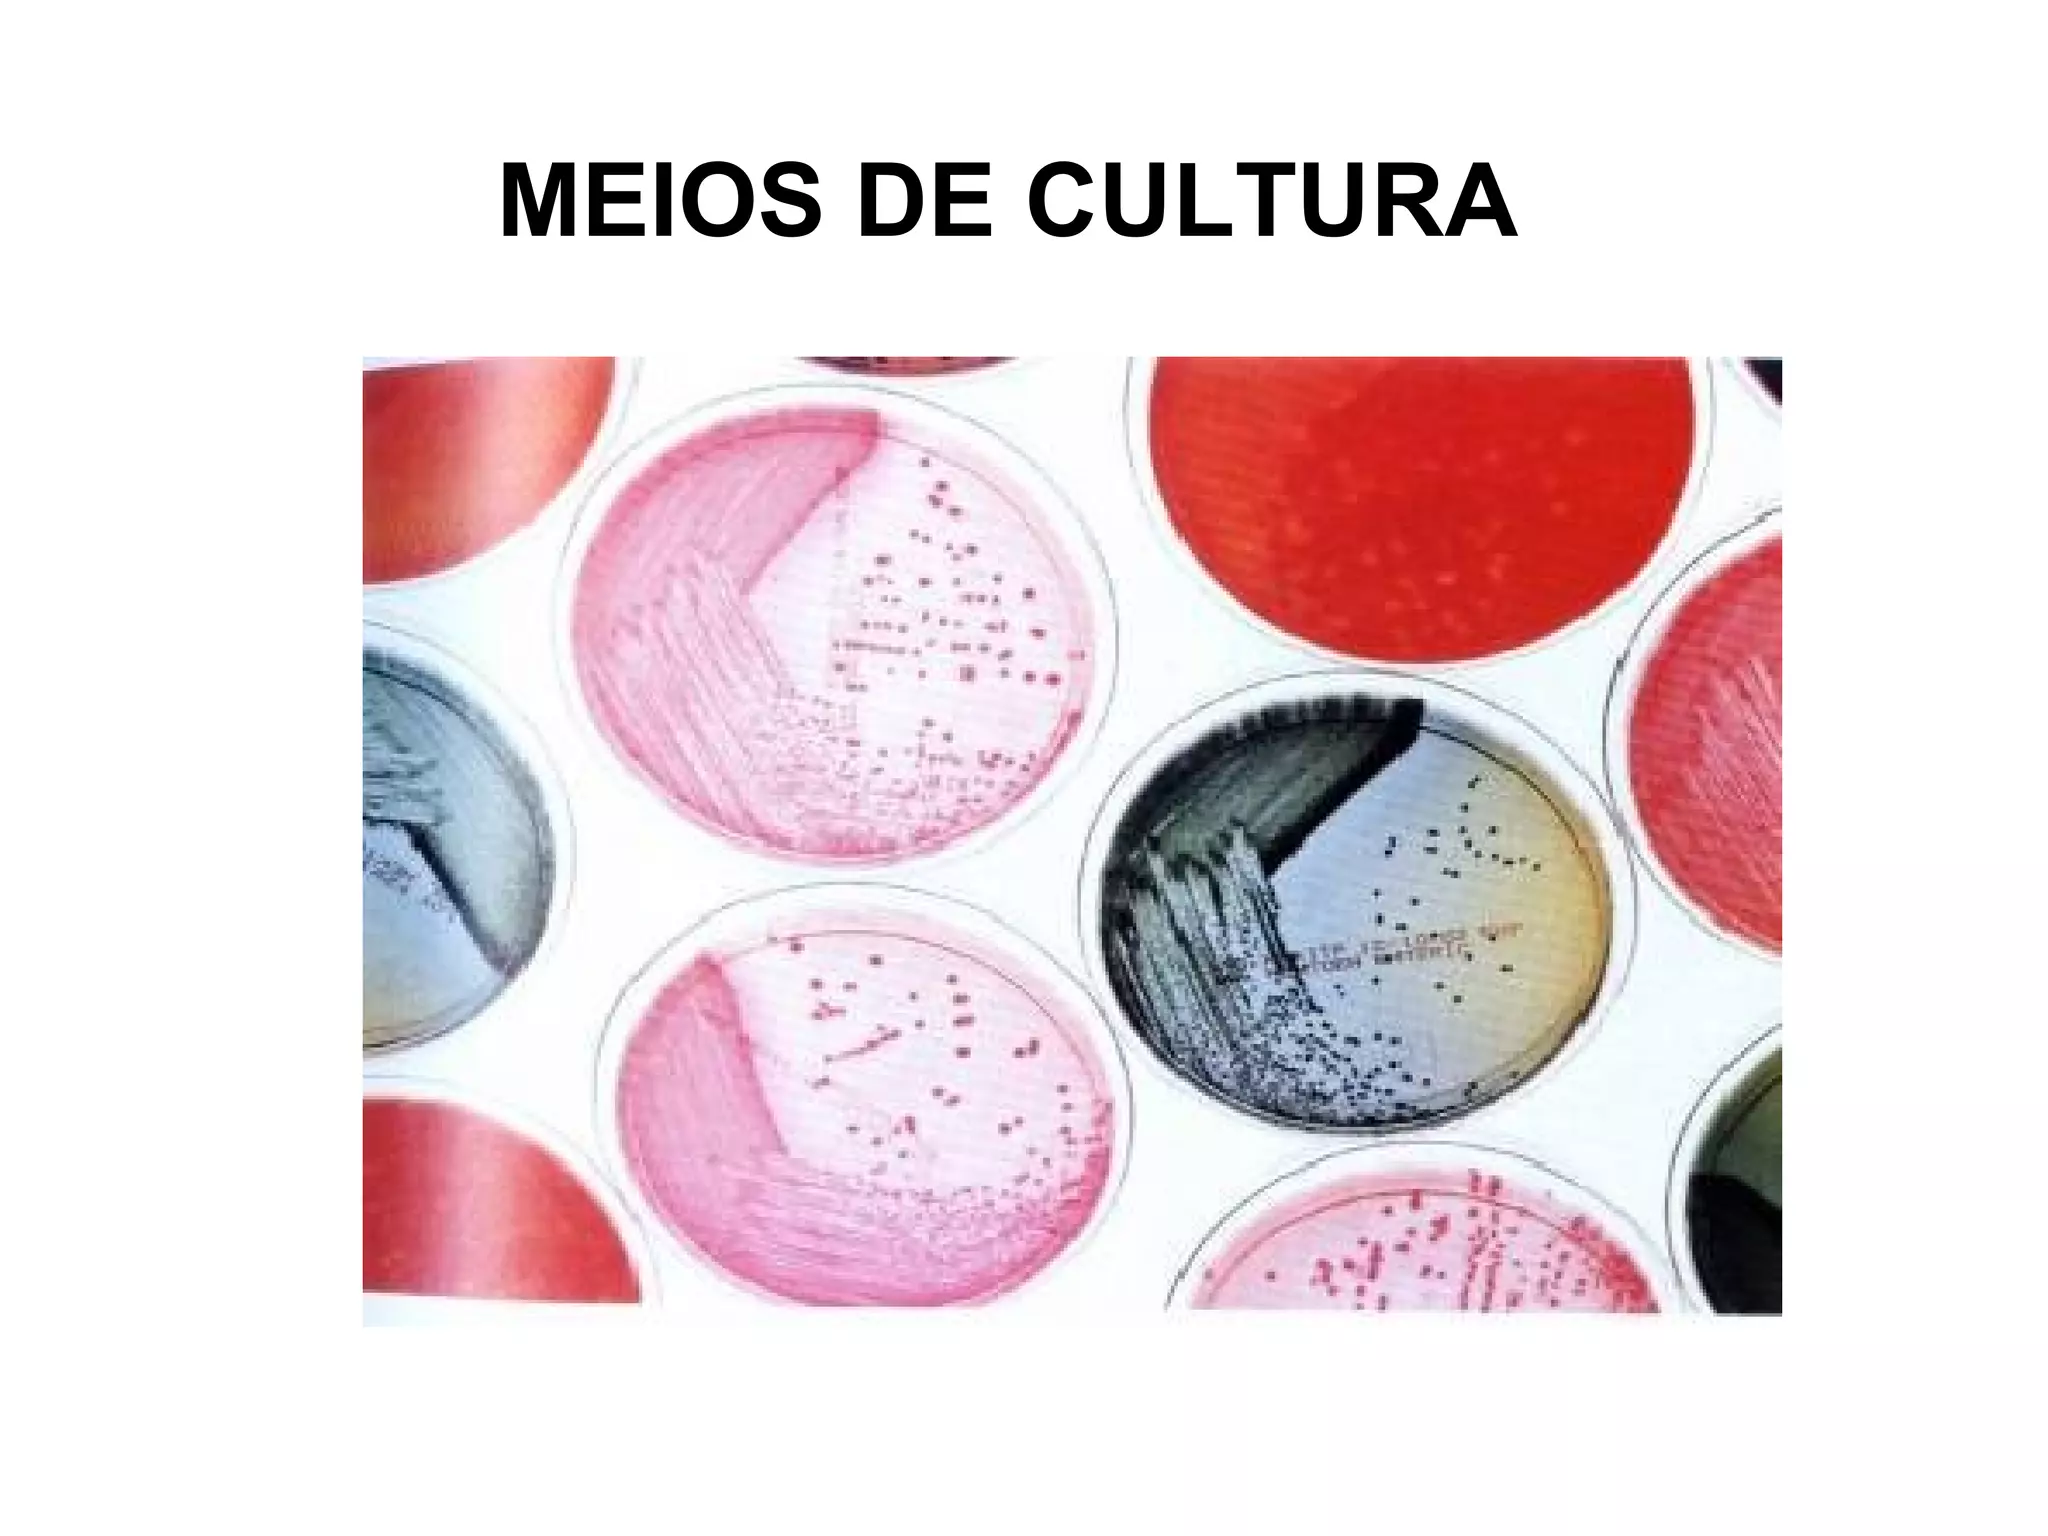
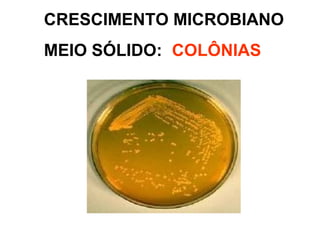
CRESCIMENTO MICROBIANO
MEIO SÓLIDO: COLÔNIAS
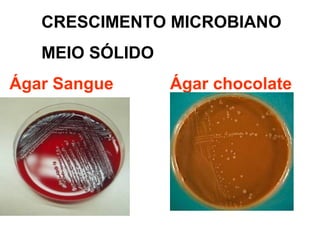
CRESCIMENTO MICROBIANO
MEIO SÓLIDO
Ágar Sangue Ágar chocolate
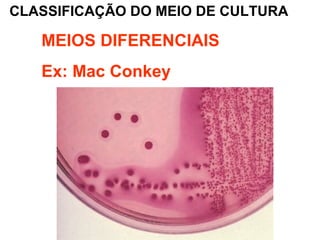
CLASSIFICAÇÃO DO MEIO DE CULTURA
MEIOS DIFERENCIAIS
Ex: Mac Conkey
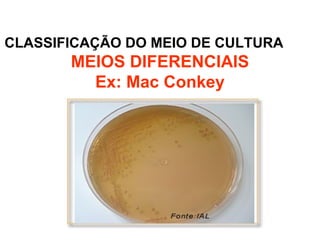
CLASSIFICAÇÃO DO MEIO DE CULTURA
MEIOS DIFERENCIAIS
Ex: Mac Conkey
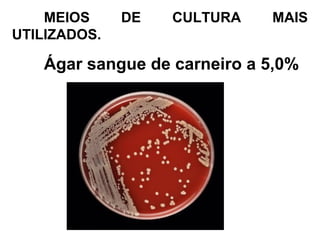
MEIOS DE CULTURA MAIS
UTILIZADOS.
Ágar sangue de carneiro a 5,0%
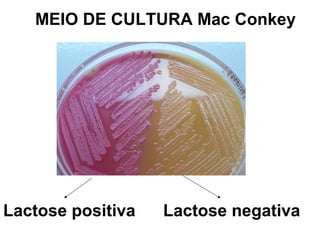
MEIO DE CULTURA Mac Conkey
Lactose positiva Lactose negativa
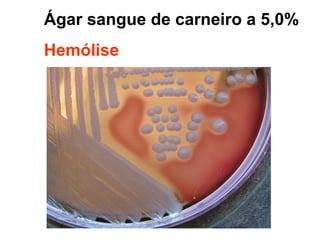
Ágar sangue de carneiro a 5,0%
Hemólise
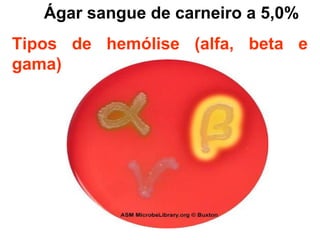
Ágar sangue de carneiro a 5,0%
Tipos de hemólise (alfa, beta e
gama)
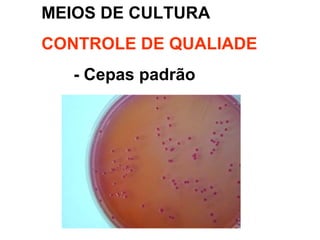
MEIOS DE CULTURA
CONTROLE DE QUALIADE
- Cepas padrão

O documento descreve os meios de cultura utilizados para o crescimento de microrganismos em laboratório. São apresentados os principais tipos de meios de acordo com a consistência (sólidos, semi-sólidos e líquidos), classificação (complexos, sintéticos, diferenciais, seletivos, de enriquecimento), condições para o crescimento de bactérias (temperatura, pH, atmosfera gasosa) e métodos de preparação e esterilização dos meios.